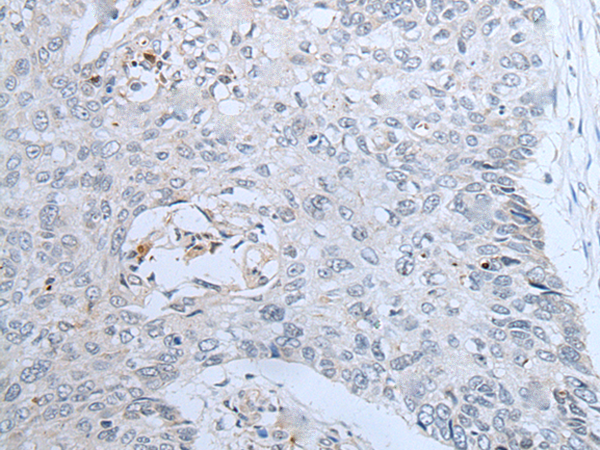

中文名稱:兔抗CENPF多克隆抗體
英文名稱: Anti-CENPF rabbit polyclonal antibody
級 別: CENF; hcp-1; CILD31; PRO1779
宿 主: Rabbit
相關(guān)類別: 一抗
反應(yīng)種屬: Human
標記 物: Unconjugate
克隆類型: rabbit polyclonal
技術(shù)規(guī)格
|
Background: |
This gene encodes a protein that associates with the centromere-kinetochore complex. The protein is a component of the nuclear matrix during the G2 phase of interphase. In late G2 the protein associates with the kinetochore and maintains this association through early anaphase. It localizes to the spindle midzone and the intracellular bridge in late anaphase and telophase, respectively, and is thought to be subsequently degraded. The localization of this protein suggests that it may play a role in chromosome segregation during mitotis. It is thought to form either a homodimer or heterodimer. Autoantibodies against this protein have been found in patients with cancer or graft versus host disease. |
|
Applications: |
ELISA, IHC |
|
Name of antibody: |
CENPF |
|
Immunogen: |
Synthetic peptide of human CENPF |
|
Full name: |
centromere protein F |
|
Synonyms: |
CENF; hcp-1; CILD31; PRO1779 |
|
SwissProt: |
P49454 |
|
ELISA Recommended dilution: |
5000-10000 |
|
IHC positive control: |
Human brain and human lung cancer |
|
IHC Recommend dilution: |
30-150 |

購物車
幫助
021-54845833/15800441009
